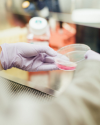

01 de Noviembre
02 de Noviembre
04 de Noviembre
05 de Noviembre
06 de Noviembre
07 de Noviembre
08 de Noviembre
CINE
Probar otra vez. Fallar otra vez. Fallar mejor
Entrada libre hasta completar aforo.Horario: 19:00
09 de Noviembre
11 de Noviembre
CINE
Las adaptaciones literarias en el cine de Manuel Antín
Entrada libre hasta completar aforo.Horario: 19:00
12 de Noviembre
CINE
Manuel Antín: tres películas con Julio Cortázar
Entrada libre hasta completar aforo.Horario: 19:00
13 de Noviembre
14 de Noviembre
SOCIEDAD
El uso de aguas no convencionales para la seguridad alimentaria
Entrada con inscripción.Horario: 09:00
15 de Noviembre
SOCIEDAD
El uso de aguas no convencionales para la seguridad alimentaria
Entrada con inscripción.Horario: 09:00
16 de Noviembre
18 de Noviembre
19 de Noviembre
SOCIEDAD
Ciencia, Tecnología e Innovación para los ODS en Iberoamérica
Entrada con inscripción.Horario: 10:00
20 de Noviembre
LITERATURA
Planeta Vulnerable III. Teatro Ecológico del siglo XXI
Entrada libre hasta completar aforo.Horario: 19:00
21 de Noviembre
22 de Noviembre
23 de Noviembre
25 de Noviembre
26 de Noviembre
27 de Noviembre
LITERATURA
Describo que escribo: Alicia Dujovne y Susana García Iglesias
Entrada libre hasta completar aforo.Horario: 19:00
POLíTICA
Tribuna EFE con Michel Temer, expresidente de Brasil
Entrada con inscripción.Horario: 12:15